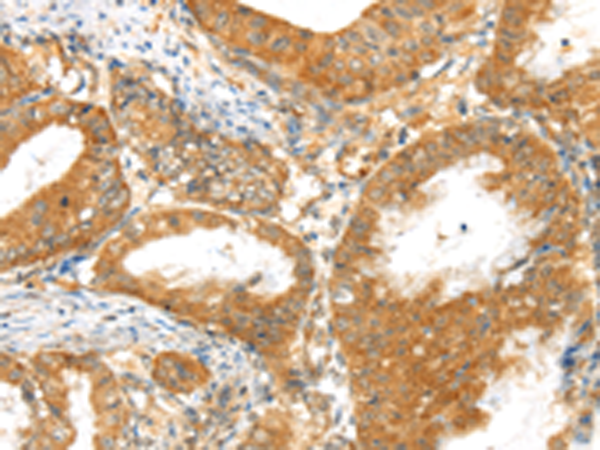

提醒成功

搜索
Rabbit Polyclonal Antibody to MPP6
-
货号:
P05501 -
别名:
VAM1; p55T; PALS2; VAM-1 -
应用:
IHC -
反应种属:
Human, Mouse -
抗体类型:
Primary antibody -
Swissprot:
Q9NZW5 -
规格:
-
数量:
-+ -
说明书:
目录价¥1980

Rabbit Polyclonal Antibody to MPP6
Description |
|---|
Members of the peripheral membrane-associated guanylate kinase (MAGUK) family function in tumor suppression and receptor clustering by forming multiprotein complexes containing distinct sets of transmembrane, cytoskeletal, and cytoplasmic signaling proteins. All MAGUKs contain a PDZ-SH3-GUK core and are divided into 4 subfamilies, DLG-like (see DLG1; MIM 601014), ZO1-like (see TJP1; MIM 601009), p55-like (see MPP1; MIM 305360), and LIN2-like (see CASK; MIM 300172), based on their size and the presence of additional domains. MPP6 is a member of the p55-like MAGUK subfamily (Tseng et al., 2001 [PubMed 11311936]). |
Specification |
|
|---|---|
| Aliases | VAM1; p55T; PALS2; VAM-1 |
| Swissprot | Q9NZW5 |
| Host/Isotype | Rabbit IgG |
| Antibody Type | Primary antibody |
| Storage | Store at 4°C short term. Aliquot and store at -20°C long term. Avoid freeze/thaw cycles. |
| Species Reactivity | Human, Mouse |
| Immunogen | Synthetic peptide of human MPP6 |
| Formulation | Purified antibody in PBS with 0.05% sodium azide and 50% glycerol. |
Application |
|
|---|---|
| IHC | 1/30-1/150 |
| ELISA | 1/2000-1/10000 |
Product Image
- The image is immunohistochemistry of paraffin-embedded Human liver cancer tissue using P05501(MPP6 Antibody) at dilution 1/40. (Original magnification: ×200)
- The image is immunohistochemistry of paraffin-embedded Human esophagus cancer tissue using P05501(MPP6 Antibody) at dilution 1/40. (Original magnification: ×200)
For Reseach Only
Application Key:WB - Western Blot | IHC - Immunohistochemistry | ICC - Immunocytochemistry | FCM - Flow Cytometry | ELISA - Enzyme-linked Immunosorbent Assay | IP - Immunoprecipitation
#P05501

相关产品















 微信/QQ登录
微信/QQ登录


 首页
首页